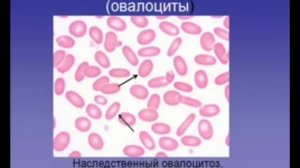
6. Патологические формы эритроцитов

13:20
13:20
2024-08-28 21:36

 1:44
1:44
1:44
1:44
2024-08-28 21:36

 9:32
9:32

 9:32
9:32
2024-08-28 21:33

 17:38
17:38

 17:38
17:38
2024-08-28 21:33

 1:08
1:08

 1:08
1:08
2026-03-21 15:50

 7:00
7:00

 7:00
7:00
2026-03-16 10:47

 2:53:36
2:53:36

 2:53:36
2:53:36
2026-04-12 21:15

 2:12:44
2:12:44

 2:12:44
2:12:44
2026-05-01 13:47

 10:54:47
10:54:47

 10:54:47
10:54:47
2026-04-30 00:03

 1:49:24
1:49:24

 1:49:24
1:49:24
2024-10-26 19:12

 2:36:33
2:36:33

 2:36:33
2:36:33
2026-04-24 17:06

 11:40:36
11:40:36

 11:40:36
11:40:36
2026-04-30 00:01

 3:01:31
3:01:31

 3:01:31
3:01:31
2025-10-02 19:15

 2:50:57
2:50:57

 2:50:57
2:50:57
2025-05-03 17:08

 2:49:04
2:49:04

 2:49:04
2:49:04
2026-04-23 12:28

 3:48:10
3:48:10

 3:48:10
3:48:10
2023-09-18 01:16

 2:48:30
2:48:30

 2:48:30
2:48:30
2023-12-23 12:24

 2:30:26
2:30:26
![Динара Швец - Ты мой самый лучший (Премьера клипа 2026)]() 3:27
3:27
![Zhamil Turan - Танцуй (Премьера клипа 2026)]() 2:59
2:59
![Murat Gamidov - Лилия (Премьера клипа 2026)]() 2:34
2:34
![Cvetocek7 - Неспокойно без тебя (Премьера клипа 2026)]() 2:34
2:34
![Ярослав Леонов - Майская роза (Премьера клипа 2026)]() 3:14
3:14
![Хуршида Намазбаева - Сени дея (Премьера клипа 2026)]() 4:17
4:17
![Рустам Батербиев - Цунами (Премьера клипа 2026)]() 2:32
2:32
![Сакит Самедов - Королева (Премьера клипа 2026)]() 2:15
2:15
![NAIMAN - На волне (Премьера клипа 2026)]() 2:13
2:13
![Соня Белькевич, КРЕСТОВ - Станцуем (Премьера клипа 2026)]() 3:25
3:25
![Дана Лахова - Сердечко (Премьера клипа 2026)]() 3:15
3:15
![ARi SAM Vii - Я обиделась (Премьера клипа 2026)]() 2:45
2:45
![Женя Белоусова - Мой поцелуй (Премьера клипа 2026)]() 3:20
3:20
![Dzhenis - Ближе ближе (Премьера 2026)]() 3:17
3:17
![NITI DILA - Белые лебеди (Премьера клипа 2026)]() 2:30
2:30
![Рейсан Магомедкеримов - Судьба связала (Премьера клипа 2026)]() 3:10
3:10
![AzaLi - Стерва (Премьера клипа 2026)]() 2:19
2:19
![Шахзод Ускенбаев - Сенсиз (Премьера клипа 2026)]() 4:52
4:52
![Sabi, MIA BOYKA - Базовый минимум (Премьера клипа 2026)]() 2:26
2:26
![Сергей Одинцов - Всю любовь тебе отдам (Премьера клипа 2026)]() 3:50
3:50
![Лакомый кусок | The Rip (2025)]() 1:52:50
1:52:50
![Опасные связи | Bone Lake (2025)]() 1:30:07
1:30:07
![Безымянная романтическая история о вторжении в дом | Untitled Home Invasion Romance (2025)]() 1:25:48
1:25:48
![Примат | Primate (2025)]() 1:32:12
1:32:12
![Элла Маккей | Ella McCay (2025)]() 1:54:47
1:54:47
![Прыгуны | Hoppers (2026)]() 1:36:21
1:36:21
![Пицца фильм | Pizza Movie (2026)]() 1:37:12
1:37:12
![Обитель зла: Последняя глава | Resident Evil: The Final Chapter (2016)]() 1:46:38
1:46:38
![Хамнет: История, вдохновившая «Гамлета» | Hamnet (2025)]() 2:05:47
2:05:47
![Завещание Анны Ли | The Testament of Ann Lee (2025)]() 2:16:48
2:16:48
![Проект «Конец света» | Project Hail Mary (2026)]() 2:36:35
2:36:35
![Частная жизнь | Vie privée (2025)]() 1:47:21
1:47:21
![Острые козырьки: Бессмертный человек | Peaky Blinders: The Immortal Man (2026)]() 1:54:08
1:54:08
![Последствия | Outcome (2026)]() 1:23:53
1:23:53
![Йети | The Yeti (2026)]() 1:33:08
1:33:08
![На помощь! | Send Help (2026)]() 1:52:59
1:52:59
![Зомби по имени Шон | Shaun of the Dead (2004)]() 1:39:31
1:39:31
![Аватар: Пламя и пепел | Avatar: Fire and Ash (2025)]() 3:17:14
3:17:14
![Обитель зла 3 | Resident Evil: Extinction (2010)]() 1:34:09
1:34:09
![Вершина | Apex (2026)]() 1:35:30
1:35:30
![Рэй и пожарный патруль Сезон 1]() 13:27
13:27
![Герой внутри]() 1:09
1:09
![Забавные медвежата]() 13:00
13:00
![Сборники «Приключения Пети и Волка»]() 1:28:31
1:28:31
![Супер Дино]() 12:41
12:41
![Люк - путешественник во времени]() 1:19:50
1:19:50
![Команда Дино. Исследователи Сезон 2]() 13:26
13:26
![Агент 203]() 21:08
21:08
![Роботы-пожарные]() 12:31
12:31
![Новогодние мультики – Союзмультфильм]() 7:04
7:04
![Врумиз. 1 сезон]() 13:10
13:10
![Оранжевая корова]() 6:30
6:30
![Майло]() 0:25
0:25
![МиниФорс Сезон 1]() 13:12
13:12
![Минифорс. Сила динозавров]() 12:51
12:51
![Зебра в клеточку]() 6:30
6:30
![Пиратская школа]() 11:06
11:06
![Шахерезада. Нерассказанные истории Сезон 1]() 23:53
23:53
![Панда и петушок Лука]() 12:12
12:12
![Космический рейнджер Роджер Сезон 1]() 11:32
11:32
![Сборник Новогодняя Десятка - Уральские Пельмени]() 1:19:08
1:19:08
![Аватар: Путь воды (2022)]() 3:12:39
3:12:39
![Давид | David (2025)]() 1:49:18
1:49:18
![мультфильм «Ну, погоди!» (1-16 серии)]() 2:31:36
2:31:36
![Лучшие в Аду (2022)]() 1:49:08
1:49:08
![Буба - Все серии]() 3:06:34
3:06:34
![Ми–Ми–Мишки 💫 Звездная история 🙃 Все серии ✨ Мультики для детей]() 2:10:31
2:10:31
![Дьявол носит Prada | The Devil Wears Prada (2006)]() 1:49:29
1:49:29
![Премьера: Предательство - фильм Андрея Медведева от 01.02.2026]() 59:17
59:17
![MAUR - Полетела (Премьера клипа 2025)]() 2:53
2:53
![Маша и Медведь. Серия 1. Первая встреча]() 6:36
6:36
![КОРОЛЬ и ШУТ /Сборник видеоклипов/]() 51:49
51:49
![Смешарики (большой сборник)]() 3:25:27
3:25:27
![КЛИПЫ 90х ⭐Русский Сборник видеоклипов]() 2:54:39
2:54:39
![Пять ночей с Фредди 2 | Five Nights at Freddy's 2 (2025)]() 1:44:11
1:44:11
![Гордость и предубеждение | Pride & Prejudice (2005)]() 2:08:21
2:08:21
![Ми–Ми–Мишки 💫 Звездная история 🙃 Все серии ✨ Мультики для детей]() 2:10:31
2:10:31
![Jakone и Kiliana - Асфальт (Mood Video)]() 2:50
2:50
![Свои. Баллада о войне [2025, драма, военный]]() 1:29:27
1:29:27
![Лева Грузовичок все серии]() 43:59
43:59

 2:30:26
2:30:26Скачать Видео с Рутуба / RuTube
| 192x144 | ||
| 320x240 | ||
| 480x360 | ||
| 640x480 |
 3:27
3:27
2026-04-09 13:37
 2:59
2:59
2026-04-15 12:45
 2:34
2:34
2026-04-29 11:20
 2:34
2:34
2026-04-23 11:07
 3:14
3:14
2026-05-02 00:31
 4:17
4:17
2026-04-27 13:24
 2:32
2:32
2026-04-29 11:10
 2:15
2:15
2026-04-12 11:24
 2:13
2:13
2026-04-14 08:26
 3:25
3:25
2026-04-30 11:44
 3:15
3:15
2026-04-21 09:41
 2:45
2:45
2026-04-12 10:21
 3:20
3:20
2026-04-15 12:53
 3:17
3:17
2026-04-10 09:39
 2:30
2:30
2026-04-28 09:53
 3:10
3:10
2026-04-29 11:37
 2:19
2:19
2026-04-23 11:42
 4:52
4:52
2026-04-27 13:31
 2:26
2:26
2026-04-23 13:18
 3:50
3:50
2026-04-21 10:41
0/0
 1:52:50
1:52:50
2026-02-04 10:11
 1:30:07
1:30:07
2026-02-06 18:40
 1:25:48
1:25:48
2026-02-26 14:41
 1:32:12
1:32:12
2026-02-17 21:38
 1:54:47
1:54:47
2026-02-11 21:47
 1:36:21
1:36:21
2026-03-27 13:35
 1:37:12
1:37:12
2026-04-06 12:20
 1:46:38
1:46:38
2026-02-25 19:41
 2:05:47
2:05:47
2026-02-06 18:40
 2:16:48
2:16:48
2026-03-12 23:31
 2:36:35
2:36:35
2026-04-11 16:06
 1:47:21
1:47:21
2026-04-09 22:40
 1:54:08
1:54:08
2026-04-13 12:20
 1:23:53
1:23:53
2026-04-17 14:43
 1:33:08
1:33:08
2026-04-15 12:24
 1:52:59
1:52:59
2026-03-27 14:10
 1:39:31
1:39:31
2026-02-16 01:07
 3:17:14
3:17:14
2026-04-02 11:34
 1:34:09
1:34:09
2026-02-25 19:41
 1:35:30
1:35:30
2026-04-30 16:00
0/0
2021-09-22 23:51
 1:09
1:09
2026-04-03 12:21
 13:00
13:00
2024-12-02 13:15
 1:28:31
1:28:31
2026-03-05 13:25
 12:41
12:41
2024-11-28 12:54
 1:19:50
1:19:50
2024-12-17 16:00
2021-09-22 22:54
 21:08
21:08
2025-01-09 16:39
2021-09-23 00:12
 7:04
7:04
2023-07-25 00:09
2021-09-24 16:00
 6:30
6:30
2022-03-31 18:49
 0:25
0:25
2026-04-10 13:19
2021-09-23 00:15
 12:51
12:51
2024-11-27 16:39
 6:30
6:30
2022-03-31 13:09
 11:06
11:06
2022-04-01 15:56
2021-09-22 23:25
 12:12
12:12
2024-11-29 14:21
2021-09-22 21:49
0/0
2026-01-01 13:59
2025-06-17 19:00
 1:49:18
1:49:18
2026-01-29 11:25
2024-12-06 21:59
2022-10-20 11:01
2024-10-24 16:05
2024-01-17 17:34
 1:49:29
1:49:29
2023-04-27 15:40
 59:17
59:17
2026-02-01 14:02
 2:53
2:53
2025-04-24 09:53
2015-02-06 15:18
2022-09-14 19:48
2025-01-24 05:04
2022-03-11 11:17
 1:44:11
1:44:11
2025-12-25 22:29
 2:08:21
2:08:21
2023-05-03 20:56
2024-01-17 17:34
 2:50
2:50
2024-07-04 15:48
2025-04-11 14:51
2022-09-16 07:26
0/0

